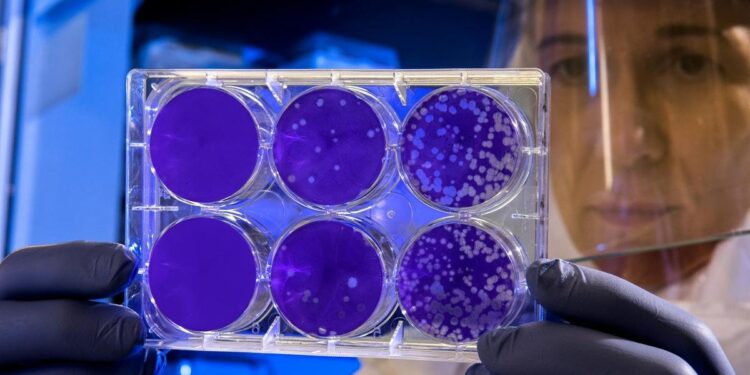

Esa frase se usa con frecuencia en el día a día y mucho entre los no creyentes, al referirse a Dios. Además, se le intenta dar una pátina de objetividad, de ajustarse a la lógica más elemental. Y acepto que es cierta en muchas ocasiones, en la vida normal, pero ¿la podemos aplicar de forma absoluta a la hora de conocer lo que nos rodea, el universo en su impresionante grandeza y en las verdades definitivas? Mi opinión es que no. Realmente, ¿tiene Dios que aparecerse a todos los humanos para que podamos creer? Nuestros sentidos nos dan una información útil para desenvolvernos en la vida diaria, pero nos proporcionan un conocimiento incompleto y equívoco de la realidad última.
Autor: Mariano Urdiales Viedma
Profecías de la Virgen que se están cumpliendo ahora
Hace siglos, Nuestra Señora del Buen Suceso reveló profecías sobre los siglos XIX y XX que hoy se están cumpliendo con asombrosa exactitud. Cuando se dice que el tiempo de…
¿Cómo ayudar a las Almas de tu familia en el Purgatorio a llegar al Cielo?
“No basta ser santo ante los hombres, sino que hay que serlo delante de Dios. ¡Recen por mí!”. Palabras impactantes del Monseñor Marengo, Obispo de Carrara, a una religiosa de María Auxiliadora…
Las 35 apariciones de la Virgen María
Descubre aquí las apariciones y el mensaje de las 35 apariciones de la Virgen María más conocidas que la Iglesia Católica reconoce, y también de otras reconocidas en diferente grado…